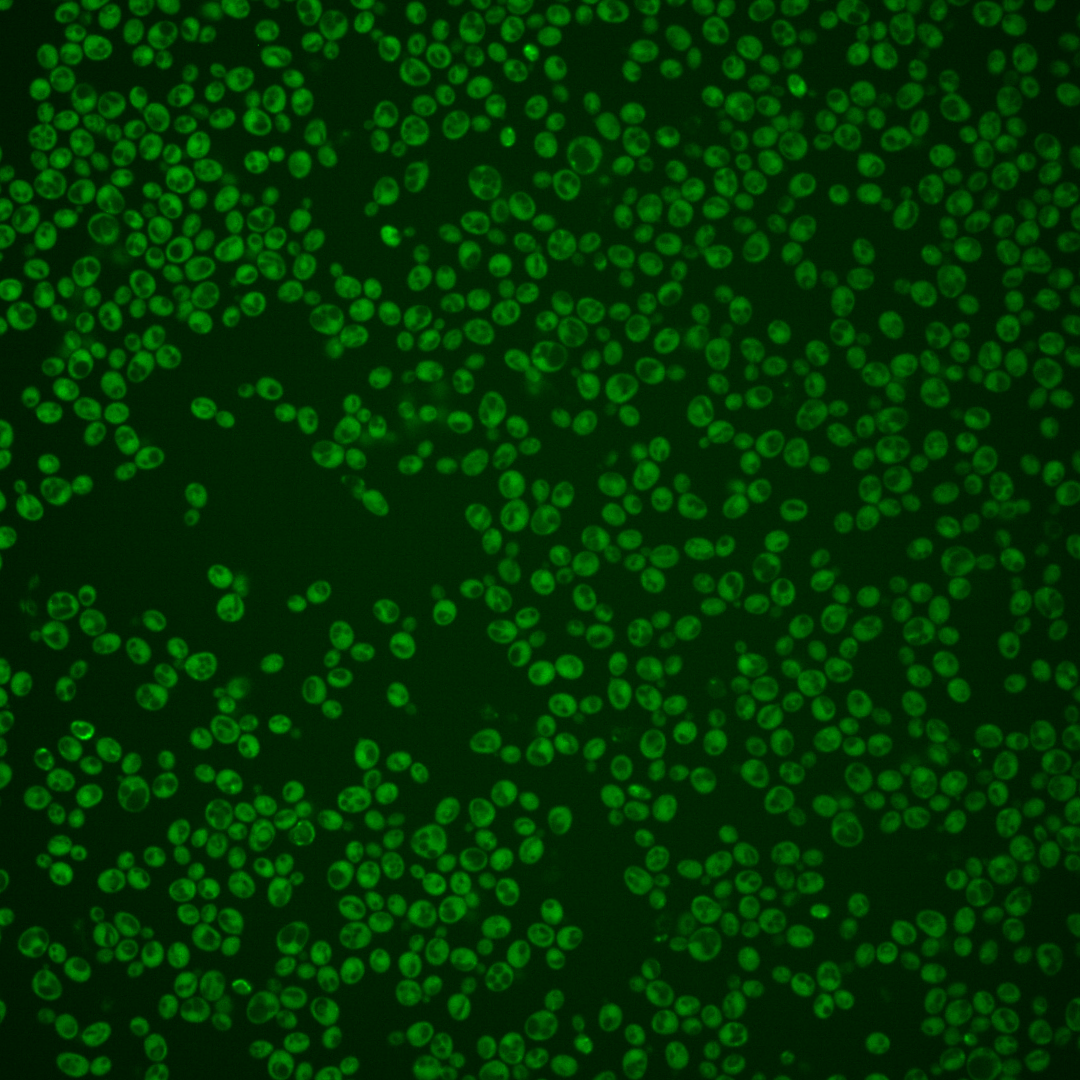
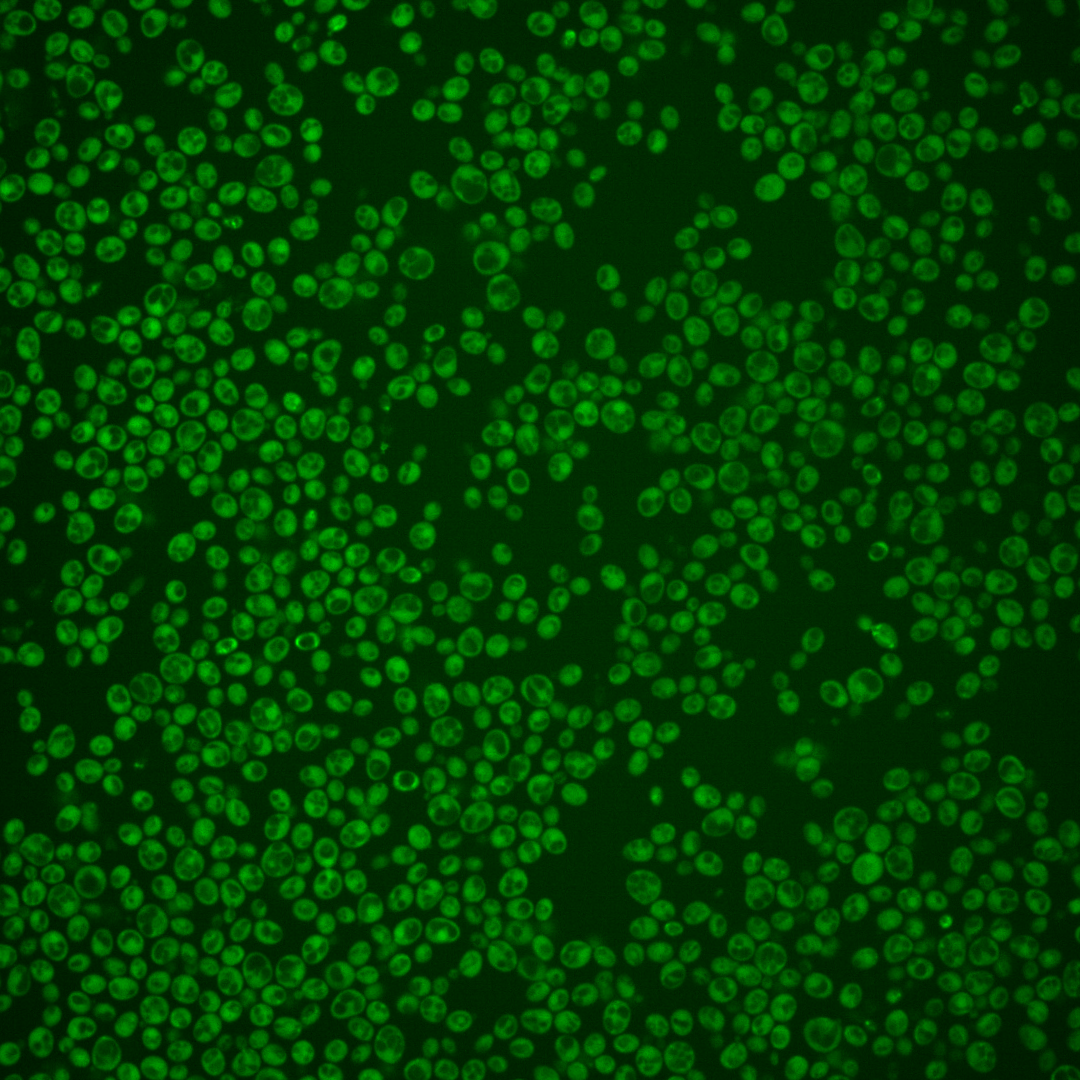
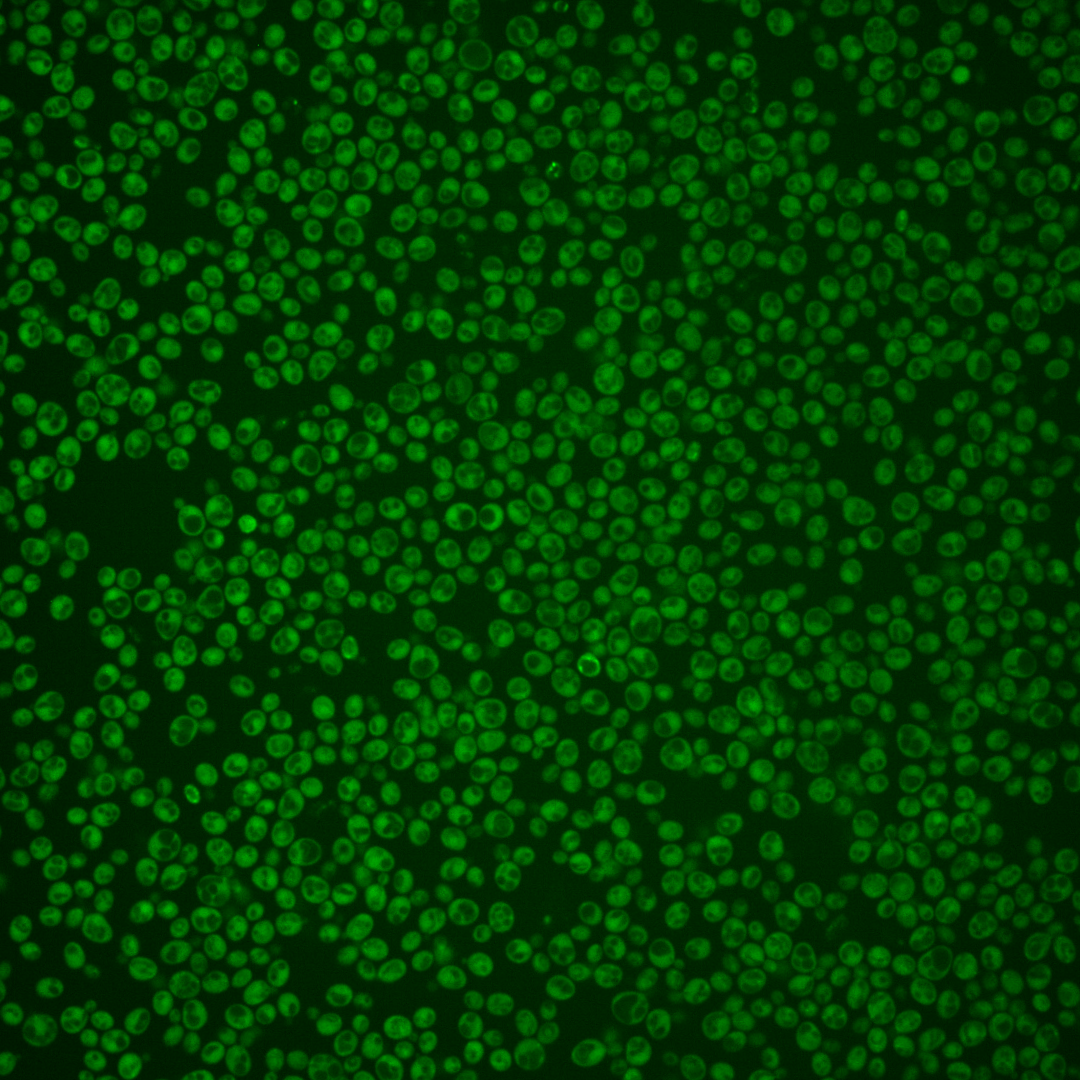
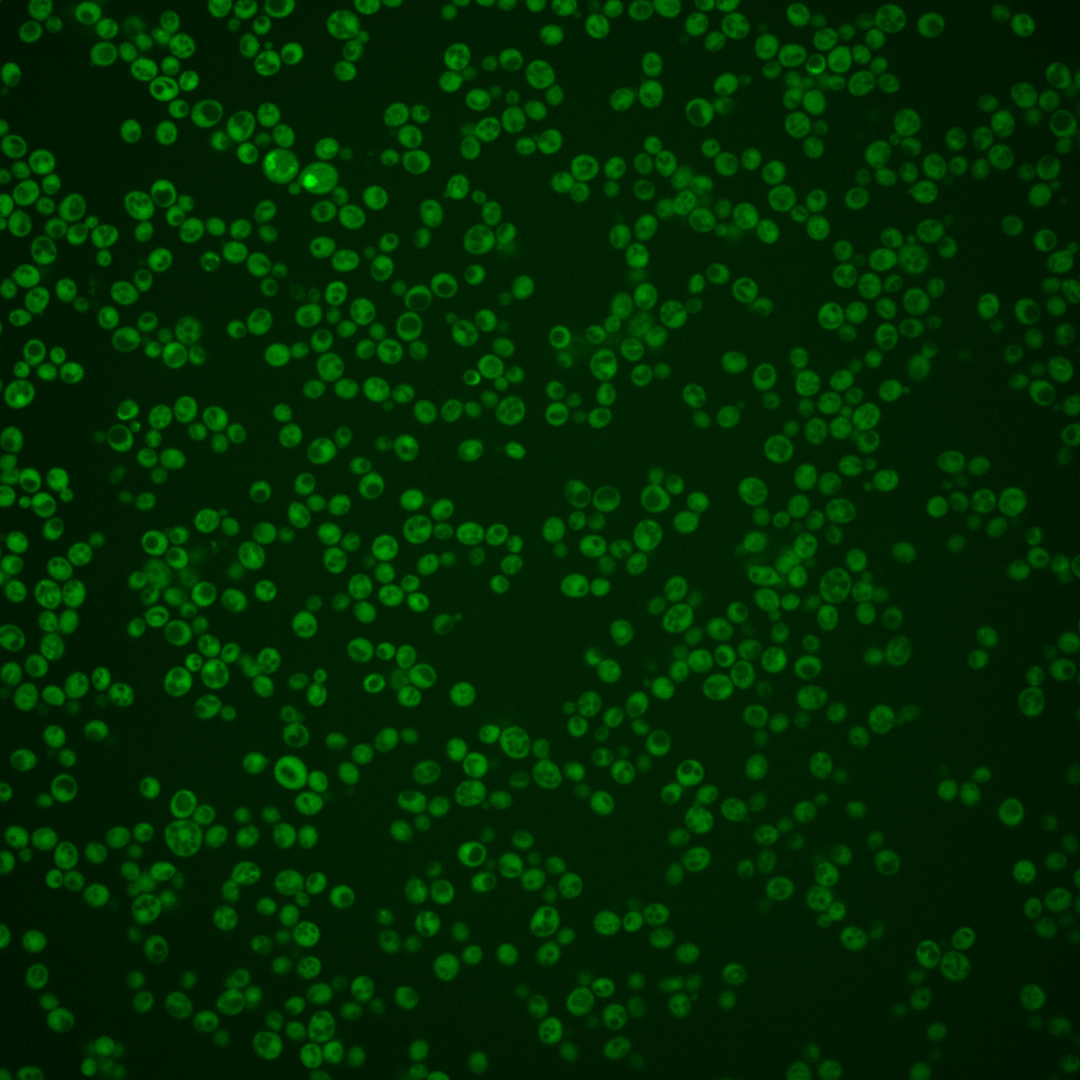
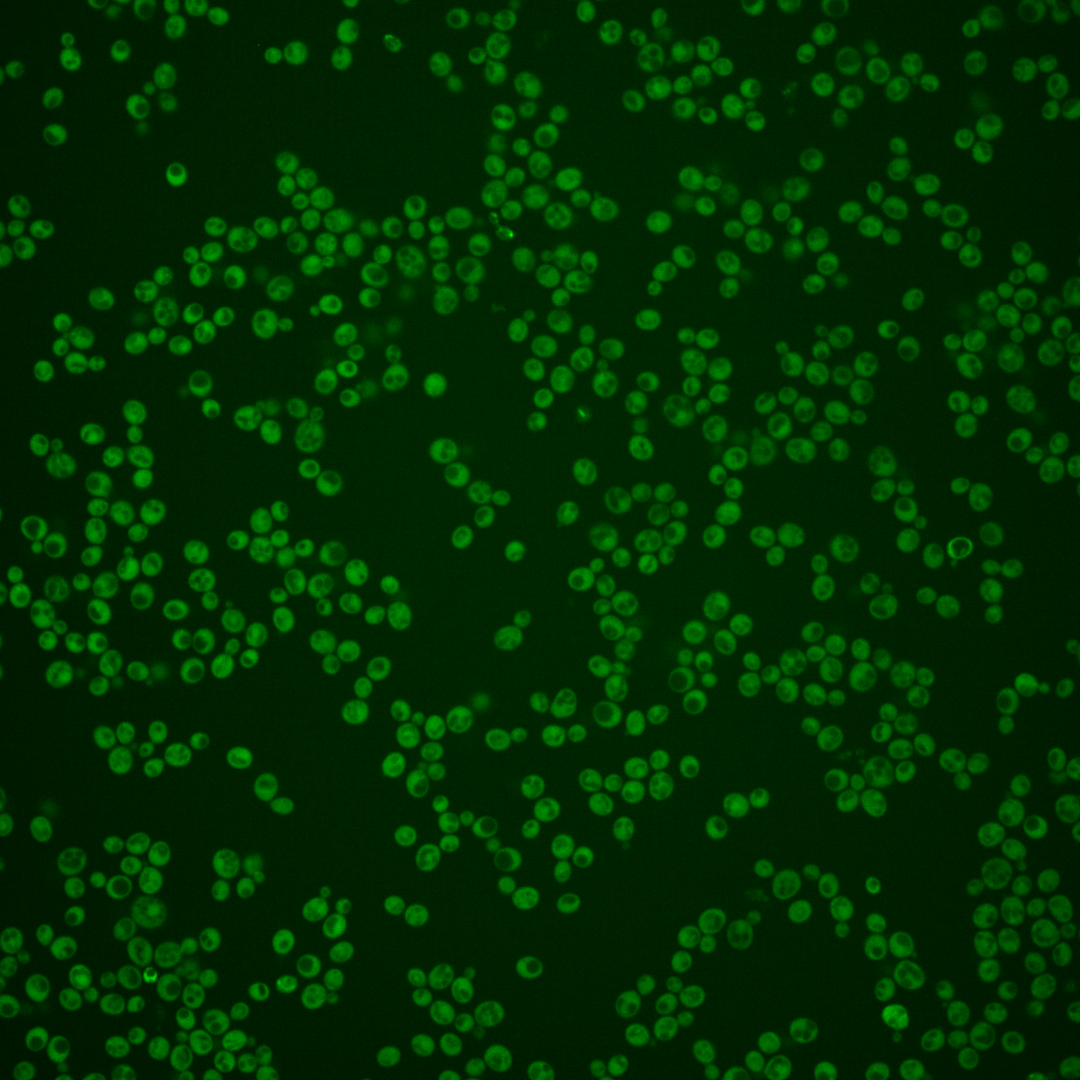
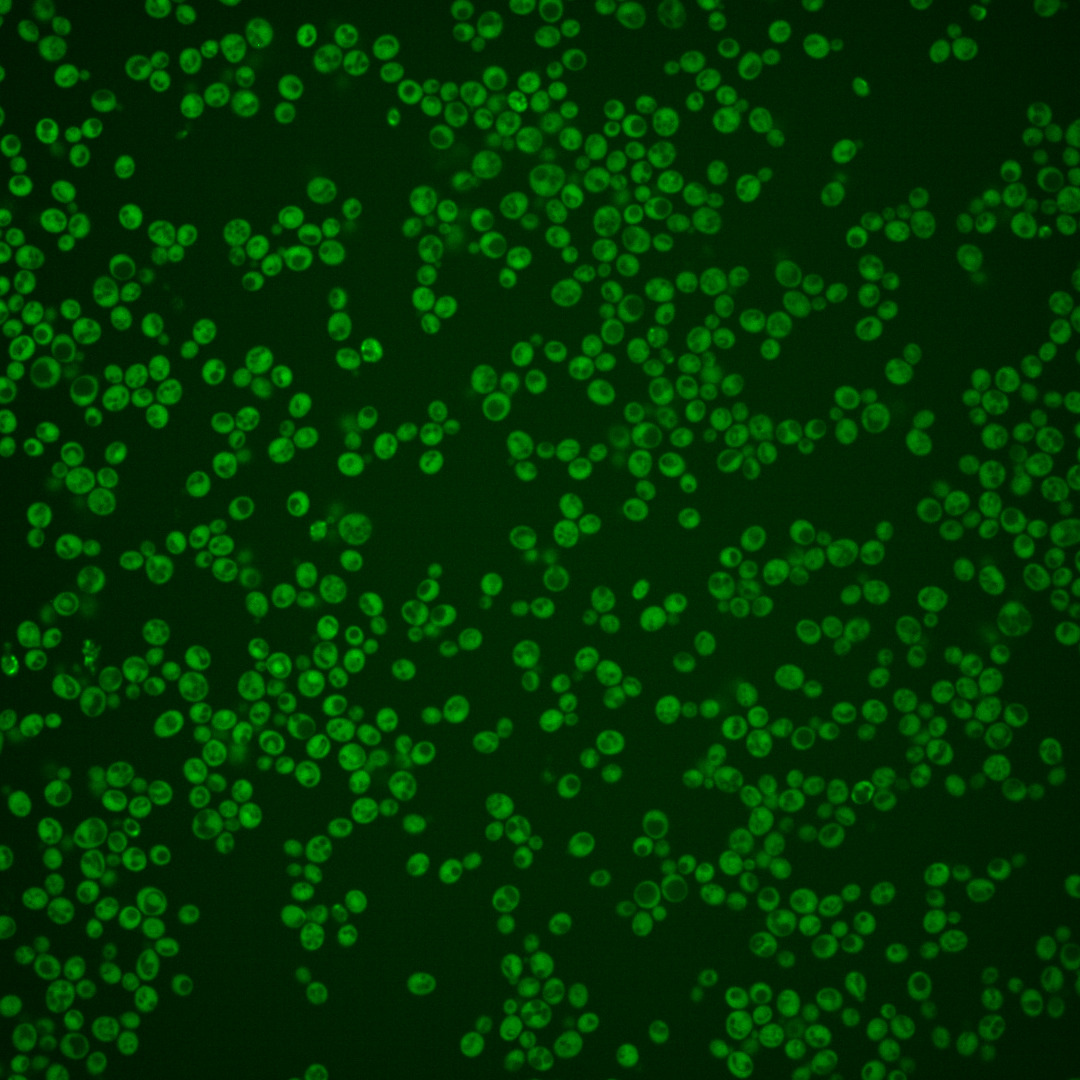

| Standard name | |
|---|---|
| Human Ortholog | |
| Description | RNA-binding protein that activates mRNA decapping directly; binds to mRNA substrate and enhances activity of decapping proteins Dcp1p and Dcp2p; has a role in translation during heat stress; protein becomes more abundant and forms cytoplasmic foci in response to DNA replication stress; EDC1 has a paralog, EDC2, that arose from the whole genome duplication |
Micrographs




















































































Sub-cellular Localization
Yeast GFP Assignment
Protein Abundance
Localization Change
External localization resources
| ensLOC | DeepLoc | |||||||||||||||||||||||
|---|---|---|---|---|---|---|---|---|---|---|---|---|---|---|---|---|---|---|---|---|---|---|---|---|
| Localization | WT1 | WT2 | WT3 | RAP60 | RAP140 | RAP220 | RAP300 | RAP380 | RAP460 | RAP540 | RAP620 | RAP700 | HU80 | HU120 | HU160 | rpd3Δ_1 | rpd3Δ_2 | rpd3Δ_3 | WT1 | WT2 | WT3 | AF100 | AF140 | AF180 |
| Cortical Patches | 0 | 0 | 0 | 1 | 0 | 0 | 0 | – | 0 | 1 | 0 | 2 | 0 | 2 | 2 | 1 | 0 | 1 | 0 | 0 | 1 | 0 | 0 | 1 |
| Bud | 0 | 1 | 0 | 2 | 1 | 6 | 0 | – | 3 | 4 | 6 | 14 | 0 | 1 | 0 | 0 | 0 | 0 | 0 | 0 | 0 | 0 | 0 | 1 |
| Bud Neck | 0 | 0 | 0 | 0 | 0 | 0 | 0 | – | 0 | 0 | 0 | 0 | 0 | 0 | 0 | 0 | 0 | 0 | 0 | 0 | 0 | 0 | 0 | 0 |
| Bud Site | 0 | 0 | 0 | 0 | 0 | 0 | 0 | – | 0 | 0 | 0 | 0 | 0 | 0 | 0 | 0 | 0 | 0 | – | – | – | – | – | – |
| Cell Periphery | 1 | 1 | 2 | 3 | 6 | 0 | 3 | – | 2 | 4 | 3 | 6 | 5 | 13 | 18 | 16 | 28 | 23 | 0 | 0 | 0 | 0 | 0 | 0 |
| Cytoplasm | 295 | 233 | 153 | 184 | 261 | 208 | 311 | – | 251 | 246 | 234 | 230 | 261 | 429 | 509 | 252 | 321 | 226 | 285 | 226 | 146 | 105 | 320 | 345 |
| Endoplasmic Reticulum | 1 | 1 | 0 | 1 | 0 | 0 | 0 | – | 1 | 2 | 1 | 7 | 0 | 3 | 2 | 9 | 10 | 13 | 2 | 0 | 1 | 0 | 3 | 3 |
| Endosome | 1 | 0 | 0 | 1 | 0 | 0 | 1 | – | 1 | 2 | 6 | 2 | 1 | 2 | 1 | 2 | 2 | 2 | 2 | 1 | 1 | 0 | 0 | 1 |
| Golgi | 1 | 0 | 1 | 0 | 1 | 0 | 0 | – | 0 | 0 | 0 | 0 | 0 | 0 | 0 | 2 | 1 | 0 | 2 | 1 | 0 | 0 | 0 | 1 |
| Mitochondria | 2 | 2 | 0 | 9 | 2 | 23 | 14 | – | 63 | 75 | 108 | 99 | 0 | 0 | 0 | 4 | 3 | 2 | 3 | 2 | 1 | 0 | 0 | 2 |
| Nucleus | 0 | 0 | 2 | 1 | 1 | 4 | 6 | – | 3 | 4 | 4 | 9 | 0 | 1 | 1 | 2 | 2 | 0 | 0 | 2 | 0 | 0 | 0 | 1 |
| Nuclear Periphery | 0 | 0 | 0 | 0 | 0 | 0 | 0 | – | 0 | 2 | 1 | 2 | 0 | 0 | 0 | 0 | 0 | 0 | 0 | 0 | 0 | 0 | 0 | 1 |
| Nucleolus | 0 | 0 | 0 | 0 | 0 | 2 | 1 | – | 0 | 0 | 1 | 0 | 0 | 0 | 0 | 0 | 0 | 0 | 0 | 0 | 0 | 0 | 0 | 0 |
| Peroxisomes | 0 | 0 | 0 | 0 | 0 | 0 | 0 | – | 0 | 0 | 0 | 0 | 0 | 0 | 0 | 0 | 0 | 0 | 0 | 0 | 0 | 0 | 0 | 0 |
| SpindlePole | 0 | 0 | 0 | 0 | 0 | 0 | 0 | – | 0 | 0 | 1 | 0 | 0 | 1 | 0 | 0 | 0 | 0 | 1 | 0 | 0 | 0 | 0 | 1 |
| Vac/Vac Membrane | 5 | 0 | 0 | 3 | 3 | 3 | 33 | – | 24 | 18 | 24 | 22 | 1 | 0 | 5 | 16 | 24 | 13 | 0 | 0 | 0 | 0 | 1 | 2 |
| Unique Cell Count | 301 | 235 | 156 | 190 | 265 | 224 | 348 | 314 | 310 | 328 | 335 | 263 | 432 | 515 | 273 | 345 | 240 | 302 | 239 | 156 | 109 | 328 | 366 | |
| Labelled Cell Count | 306 | 238 | 158 | 205 | 275 | 246 | 369 | 348 | 358 | 389 | 393 | 268 | 452 | 538 | 304 | 391 | 280 | 302 | 239 | 156 | 109 | 328 | 366 | |
Yeast GFP Assignment
Protein Abundance
| Screen | WT1 | WT2 | WT3 | RAP60 | RAP140 | RAP220 | RAP300 | RAP380 | RAP460 | RAP540 | RAP620 | RAP700 | HU80 | HU120 | HU160 | rpd3Δ_1 | rpd3Δ_2 | rpd3Δ_3 | AF100 | AF140 | AF180 |
|---|---|---|---|---|---|---|---|---|---|---|---|---|---|---|---|---|---|---|---|---|---|
| Mean Cell GFP Intensity (1e-4) | 6.8 | 6.7 | 7.1 | 7.2 | 8.2 | 5.3 | 6.5 | – | 5.6 | 5.6 | 5.6 | 5.5 | 8.7 | 9.0 | 9.5 | 11.8 | 12.1 | 12.0 | 6.6 | 7.2 | 7.4 |
| Std Deviation (1e-4) | 0.9 | 0.8 | 1.2 | 1.2 | 1.3 | 1.3 | 1.3 | – | 1.1 | 1.1 | 1.1 | 0.9 | 1.0 | 1.2 | 1.3 | 2.2 | 2.4 | 2.7 | 0.7 | 1.2 | 1.3 |
| Intensity Change (Log2) | – | – | – | 0.02 | 0.2 | -0.42 | -0.13 | – | -0.36 | -0.34 | -0.35 | -0.38 | 0.28 | 0.34 | 0.41 | 0.73 | 0.76 | 0.75 | -0.12 | 0.02 | 0.05 |
Localization Change
| Localization | RAP60 | RAP140 | RAP220 | RAP300 | RAP380 | RAP460 | RAP540 | RAP620 | RAP700 | HU80 | HU120 | HU160 | rpd3Δ_1 | rpd3Δ_2 | rpd3Δ_3 |
|---|---|---|---|---|---|---|---|---|---|---|---|---|---|---|---|
| Cortical Patches | 0 | 0 | 0 | 0 | – | 0 | 0 | 0 | 0 | 0 | 0 | 0 | 0 | 0 | 0 |
| Bud | 0 | 0 | 0 | 0 | – | 0 | 0 | 0 | 0 | 0 | 0 | 0 | 0 | 0 | 0 |
| Bud Neck | 0 | 0 | 0 | 0 | – | 0 | 0 | 0 | 0 | 0 | 0 | 0 | 0 | 0 | 0 |
| Bud Site | 0 | 0 | 0 | 0 | – | 0 | 0 | 0 | 0 | 0 | 0 | 0 | 0 | 0 | 0 |
| Cell Periphery | 0 | 0 | 0 | 0 | – | 0 | 0 | 0 | 0 | 0 | 0 | 0 | 2.3 | 3.0 | 3.3 |
| Cytoplasm | -0.7 | 0.3 | -2.3 | -3.3 | – | -5.3 | -5.4 | -6.9 | -7.3 | 1.1 | 1.3 | 0.7 | -2.5 | -2.3 | -1.9 |
| Endoplasmic Reticulum | 0 | 0 | 0 | 0 | – | 0 | 0 | 0 | 0 | 0 | 0 | 0 | 0 | 0 | 3.0 |
| Endosome | 0 | 0 | 0 | 0 | – | 0 | 0 | 0 | 0 | 0 | 0 | 0 | 0 | 0 | 0 |
| Golgi | 0 | 0 | 0 | 0 | – | 0 | 0 | 0 | 0 | 0 | 0 | 0 | 0 | 0 | 0 |
| Mitochondria | 0 | 0 | 4.1 | 0 | – | 6.0 | 6.7 | 8.1 | 7.6 | 0 | 0 | 0 | 0 | 0 | 0 |
| Nucleus | 0 | 0 | 0 | 0 | – | 0 | 0 | 0 | 0 | 0 | 0 | 0 | 0 | 0 | 0 |
| Nuclear Periphery | 0 | 0 | 0 | 0 | – | 0 | 0 | 0 | 0 | 0 | 0 | 0 | 0 | 0 | 0 |
| Nucleolus | 0 | 0 | 0 | 0 | – | 0 | 0 | 0 | 0 | 0 | 0 | 0 | 0 | 0 | 0 |
| Peroxisomes | 0 | 0 | 0 | 0 | – | 0 | 0 | 0 | 0 | 0 | 0 | 0 | 0 | 0 | 0 |
| SpindlePole | 0 | 0 | 0 | 0 | – | 0 | 0 | 0 | 0 | 0 | 0 | 0 | 0 | 0 | 0 |
| Vacuole | 0 | 0 | 0 | 4.0 | – | 3.5 | 3.1 | 3.5 | 3.3 | 0 | 0 | 0 | 3.1 | 3.4 | 3.0 |
External localization resources
Images






























Protein Concentration and Protein Localization Data
| R1 | R2 | R3 | ||||||||||||||||
|---|---|---|---|---|---|---|---|---|---|---|---|---|---|---|---|---|---|---|
| G1 Pre-START | G1 Post-START | S/G2 | Metaphase | Anaphase | Telophase | G1 Pre-START | G1 Post-START | S/G2 | Metaphase | Anaphase | Telophase | G1 Pre-START | G1 Post-START | S/G2 | Metaphase | Anaphase | Telophase | |
| Concentration | 1.9877 | 2.115 | 2.268 | 1.895 | 1.7362 | 2.1537 | 3.496 | 3.3424 | 3.3032 | 3.111 | 3.0946 | 3.26 | 5.237 | 5.3936 | 5.2579 | 5.2271 | 4.549 | 4.9113 |
| Actin | 0.0359 | 0.0082 | 0.0267 | 0.0027 | 0.0279 | 0.0031 | 0.0483 | 0.0024 | 0.0163 | 0.038 | 0.003 | 0.0141 | 0.0408 | 0.0202 | 0.0112 | 0.033 | 0.0299 | 0.0176 |
| Bud | 0.0007 | 0.0013 | 0.0046 | 0.0006 | 0.0004 | 0.0004 | 0.0013 | 0.0042 | 0.0012 | 0.0044 | 0.0003 | 0.0005 | 0.0014 | 0.0003 | 0.0048 | 0.0008 | 0.0012 | 0.0002 |
| Bud Neck | 0.0035 | 0.0004 | 0.0026 | 0.0005 | 0.0017 | 0.003 | 0.0018 | 0.0002 | 0.0004 | 0.0116 | 0.0006 | 0.0029 | 0.0115 | 0.0001 | 0.0003 | 0.0052 | 0.0017 | 0.001 |
| Bud Periphery | 0.0008 | 0.0008 | 0.0035 | 0.0003 | 0.0005 | 0.0003 | 0.0014 | 0.0047 | 0.0014 | 0.004 | 0.0004 | 0.0008 | 0.0021 | 0.0002 | 0.0014 | 0.0007 | 0.0017 | 0.0001 |
| Bud Site | 0.0017 | 0.0064 | 0.0047 | 0.0006 | 0.001 | 0.0002 | 0.0057 | 0.0086 | 0.001 | 0.0234 | 0.0008 | 0.0003 | 0.0087 | 0.0005 | 0.0043 | 0.0231 | 0.0015 | 0.0002 |
| Cell Periphery | 0.0002 | 0.0004 | 0.0002 | 0.0001 | 0.0001 | 0.0001 | 0.0002 | 0.0002 | 0.0001 | 0.0019 | 0.0001 | 0.0001 | 0.0006 | 0.0001 | 0.0001 | 0.0004 | 0.0004 | 0 |
| Cytoplasm | 0.7203 | 0.7693 | 0.7803 | 0.8036 | 0.7175 | 0.8441 | 0.742 | 0.8721 | 0.8805 | 0.7383 | 0.7831 | 0.8696 | 0.691 | 0.8869 | 0.8131 | 0.8105 | 0.7713 | 0.9039 |
| Cytoplasmic Foci | 0.0224 | 0.0109 | 0.014 | 0.0192 | 0.0168 | 0.0081 | 0.0337 | 0.0114 | 0.0088 | 0.0389 | 0.0287 | 0.0122 | 0.0352 | 0.0059 | 0.0196 | 0.0256 | 0.0401 | 0.0182 |
| Eisosomes | 0.0004 | 0.0002 | 0.0003 | 0 | 0.0002 | 0 | 0.0003 | 0 | 0.0001 | 0.0007 | 0.0001 | 0.0001 | 0.0011 | 0 | 0.0001 | 0.0001 | 0.0001 | 0 |
| Endoplasmic Reticulum | 0.0108 | 0.0047 | 0.0053 | 0.0033 | 0.008 | 0.0019 | 0.0089 | 0.0029 | 0.0022 | 0.003 | 0.0016 | 0.0029 | 0.0064 | 0.0028 | 0.0046 | 0.0019 | 0.0027 | 0.0018 |
| Endosome | 0.0174 | 0.0044 | 0.0144 | 0.0273 | 0.0314 | 0.0094 | 0.0337 | 0.0043 | 0.0053 | 0.0331 | 0.0338 | 0.0113 | 0.0289 | 0.0066 | 0.0115 | 0.0127 | 0.0168 | 0.0044 |
| Golgi | 0.0033 | 0.0005 | 0.0043 | 0.0013 | 0.0059 | 0.001 | 0.0107 | 0.0007 | 0.0034 | 0.0124 | 0.0151 | 0.0052 | 0.0105 | 0.0007 | 0.0076 | 0.0038 | 0.016 | 0.0026 |
| Lipid Particles | 0.0025 | 0.0005 | 0.006 | 0.0021 | 0.0169 | 0.0015 | 0.0058 | 0.0002 | 0.0018 | 0.0052 | 0.0337 | 0.0019 | 0.0135 | 0.0002 | 0.0012 | 0.0031 | 0.0144 | 0.0009 |
| Mitochondria | 0.002 | 0.0005 | 0.0025 | 0.0011 | 0.0134 | 0.0005 | 0.0063 | 0.0007 | 0.0018 | 0.0073 | 0.0175 | 0.011 | 0.0115 | 0.0002 | 0.0031 | 0.0013 | 0.0064 | 0.0015 |
| None | 0.1478 | 0.1815 | 0.1157 | 0.1086 | 0.0944 | 0.1187 | 0.0599 | 0.0733 | 0.0689 | 0.047 | 0.0441 | 0.0445 | 0.0919 | 0.0728 | 0.0995 | 0.0537 | 0.0473 | 0.0417 |
| Nuclear Periphery | 0.0096 | 0.0029 | 0.0029 | 0.013 | 0.0271 | 0.0033 | 0.011 | 0.0009 | 0.0013 | 0.0025 | 0.0024 | 0.0051 | 0.0106 | 0.0006 | 0.0045 | 0.0006 | 0.0009 | 0.0003 |
| Nucleolus | 0.0005 | 0.0002 | 0.0014 | 0.0004 | 0.0018 | 0.0003 | 0.0008 | 0.0001 | 0 | 0.0006 | 0.0003 | 0.0001 | 0.0008 | 0 | 0.0001 | 0.0004 | 0.0002 | 0 |
| Nucleus | 0.0041 | 0.0027 | 0.0029 | 0.0041 | 0.0112 | 0.0014 | 0.0085 | 0.0094 | 0.0016 | 0.0021 | 0.0015 | 0.0113 | 0.0031 | 0.0007 | 0.0064 | 0.0013 | 0.0012 | 0.001 |
| Peroxisomes | 0.0045 | 0.0003 | 0.0014 | 0.002 | 0.0089 | 0.0002 | 0.008 | 0.0015 | 0.0017 | 0.0106 | 0.0232 | 0.0032 | 0.0166 | 0.0001 | 0.0043 | 0.0168 | 0.0367 | 0.0034 |
| Punctate Nuclear | 0.0091 | 0.0023 | 0.0027 | 0.0047 | 0.01 | 0.0014 | 0.0053 | 0.0006 | 0.0011 | 0.011 | 0.0052 | 0.0012 | 0.0074 | 0.0002 | 0.0009 | 0.001 | 0.0081 | 0.0006 |
| Vacuole | 0.0019 | 0.0016 | 0.0028 | 0.0036 | 0.0027 | 0.0009 | 0.005 | 0.0013 | 0.001 | 0.0031 | 0.0027 | 0.0011 | 0.0038 | 0.0009 | 0.0011 | 0.0035 | 0.0009 | 0.0004 |
| Vacuole Periphery | 0.0009 | 0.0002 | 0.0006 | 0.0011 | 0.0019 | 0.0003 | 0.0016 | 0.0002 | 0.0003 | 0.0008 | 0.0019 | 0.0006 | 0.0026 | 0.0001 | 0.0003 | 0.0005 | 0.0004 | 0.0001 |
Sequencing Data
| R1 | R2 | |||||||||
|---|---|---|---|---|---|---|---|---|---|---|
| G1 Post-START | S/G2 | Metaphase | Anaphase | Telophase | G1 Post-START | S/G2 | Metaphase | Anaphase | Telophase | |
| Gene Expression | 24.0325 | 13.077 | 6.9312 | 16.428 | 28.4497 | 8.3545 | 14.6388 | 17.848 | 11.6457 | 16.4433 |
| Translational Efficiency | 1.5863 | 3.2141 | 4.3109 | 1.4908 | 1.3614 | 5.1542 | 2.6799 | 2.5123 | 3.2293 | 2.2762 |
Hit Data
| Dataset | Hit |
|---|---|
| Protein Concentration | ✘ |
| Protein Localization | ✘ |
| Gene Expression | ✘ |
| Translational Efficiency | ✘ |
Endocytosis
| Temp | Actin Patch (Sac6-tdTomato) | Cortical Patch (Sla1-GFP) | Late Endosome (Snf7-GFP) | Vacuole (Vph1-GFP) |
|---|---|---|---|---|
| 37℃ | ||||
| RT |
Cell Cycle Omics
CYCLoPs (Edc1-GFP)
| Gene / Allele | Actin Patch (Sac6-tdTomato) | Cortical Patch (Sla1-GFP) | Late Endosome (Snf7-GFP) | Vacuole (Sac6-tdTomato) |
|---|
| Gene | Images |
|---|
| Gene | Images |
|---|
Images are not yet available
Images are not yet available